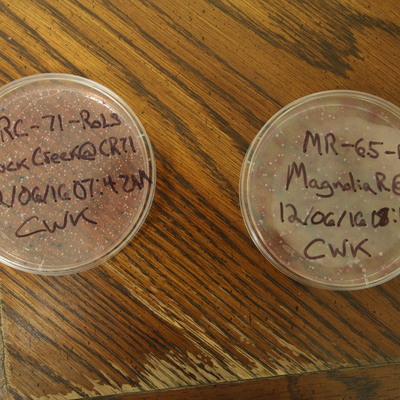
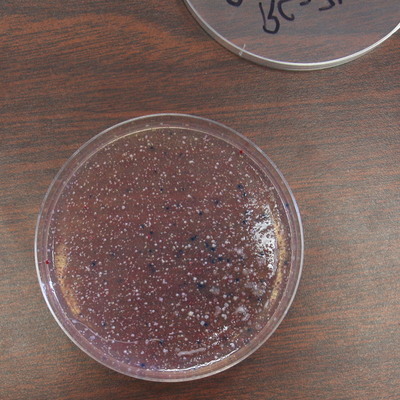

This dataset is inactive (last observation on 31 January 2020).
Dataset
Mobile Baykeeper Team

Dataset by Mobile Baykeeper
Dataset summary
Recent photos
-

at Park Ave., 6 January 2017 -

at Park Ave., 6 January 2017 -

Rock Creek @ County Road 71 (College Street), 20 December 2016 -

Rock Creek @ County Road 71 (College Street), 20 December 2016 -
Rock Creek @ County Road 71 (College Street), 6 December 2016 -
Rock Creek @ County Road 71 (College Street), 6 December 2016 -
TMC at Stanton, 8 December 2016 -
TMC at Stanton, 8 December 2016 -
TMC at Stanton, 8 December 2016 -

Magnolia River at County Rd 65, 6 December 2016 -
TMC at Stanton, 1 November 2016 -
TMC at Stanton, 1 November 2016 -
TMC at Stanton, 1 November 2016 -
TMC at Stanton, 1 November 2016 -
TMC at Stanton, 1 November 2016 -

US Hwy 43 Creek along Telegraph Road , 19 November 2016 -

US Hwy 43 Creek along Telegraph Road , 19 November 2016 -

US Hwy 43 Creek along Telegraph Road , 19 November 2016 -

TSBS, 19 November 2016 -

TSBS, 19 November 2016